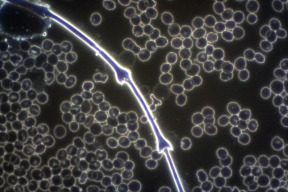
parazitismus

Parazitismus
- Podrobnosti
- Speciály CFP! / zdraví|
- 29. srpen 2014|
- Jolana|
- 10460 x
Parazitismus je vztah dvou organismů, z něhož jeden organismus (parazit - cizopasník) má zisk a druhý organismus na něj doplácí (hostitel). Parazit se může živit buďto tkáněmi samotného hostitele (aniž by se ho snažil zabít, naopak potřebuje si hostitele udržovat co nejdéle, aby na něm mohl parazitovat, prodlouží tímto život i sám sobě). Také se může přiživovat na jeho potravě či jinak profitovat z hostitelova organismu nebo jeho činnosti a snižovat přitom jeho fyzickou zdatnost.Parazitismus má velmi negativní vliv na nervovou soustavu.
Proč o parazitech nevíme??
V tomto směru nás nikdo nevzdělal, ani škola, ani rodiče, ani lékaři. Je to smutné, protože právě parazitologie (od plísní počínaje, přes viry , bakterie, malé parazity apod., až po velké parazity), je příčinou převážné většiny onemocnění.
Pokud máme tělo k tomu všemu ještě překyselené a zatížené toxiny, chemikáliemi, těžkými kovy apod. různým formám parazitismu se v organismu pak daří mnohem lépe.
Nejvíce v obraze jsou doktoři přírodních věd a veterináři. Pro ně tato skutečnost není překvapením, řeší takové věci na denním pořádku. Vážíme si toho, pokud se najdou i lékaři z klasické západní medicíny, kteří postupně začínají spojovat souvislosti mezi nemocí (důsledek) a právě skutečnou příčinou, která se nachází ve zmíněném textu.
Klasická (ne)řešení nemocí
To nejběžnější z mikrobiologie, co lékaři často uvádějí jako příčinu potíží, je např. streptokok, stafylokok, chřipkové viry, někdy borrelie, chlamydie, kvasinky apod. U zjištěných bakterií se pak nasadí většinou antibiotika. Na ty si postupně časem tyto patogeny vytváří rezistenci a bohužel tato cesta není dost často vyřešením situace, ale potlačení symptomu, který v daný okamžik pravděpodobně dočasně zabere.
Jedna nejmenovaná paní lékařka si postěžovala, že za celou její mnohaletou praxi se ještě nesetkala s laboratoří, která by uměla parazity najít, přestože občas vzorky na rozbor posílá a podle symptomů klientů parazity tuší. Testy se vracejí negativní, což lékaře časem odradí, aby to ještě zkoušel. Našich parazitologických laboratoří je málo. Nejsou tak dobře vybaveny jako pracoviště bakteriologů a virologů.
Testovací zařízení??
Dalším úskalím jsou samotné testy. Test ELISA, který se často používá ke stanovení protilátek, je levný a chybový. Selhává i u průzkumu borrelie. Kolektiv lékařů, vedený MUDr. Barťoňkem, z pražské kliniky zaměřené na borrelii, přiznává, že je falešně negativní z 50 - 70%.
A na těchto testech závisí zdraví tisíců lidí !
Všude tam, kde hledáme protilátky a ne přímo parazita, může dojít k chybě.
Podle MUDr. Miroslava Mikuleckého, CSc, z kliniky infektologie a geografické medicíny v Bratislavě, organismus nemusí z nějakého důvodu protilátky tvořit - buď má sníženou imunitu nebo malý počet jedinců nemusí vyvolat imunitní odpověď.
Proč se někdy nenajdou v našem těle protilátky proti parazitům ani v případě, že klient donese lékaři úlovek a fyzický důkaz?
Jedno z možných vysvětlení je, že organismus netvoři protilátky proti VROZENÝM infekcím. Je naivní se domnívat, že parazit se neprožere placentou, když je schopen se dostat přes střevní stěnu. Všechno, co má v těle matka, může mít i dítě. Rodinní příslušníci mívají podobné parazitární zatížení. Potom proti těmto prastarým zátěžím tělo nebojuje.
Pokoušet se proto zbavit se virů a bakterií bez předchozího odčervení je marná práce. A naopak i u velmi starých lidí se dá dosáhnout, že jejich orgány, zbavené parazitů, vykazují ideální hodnoty.
Zbavte se také stresu a lidských parazitů ve vašem životě, pracujte na vztazích.
Vnější parazité přitahují ty vnitřní !!!

Komentáře
Facebook komentáře
Nejčtenější za poslední týden
- Co pro dnešní den 26.1.2026 před 70-ti lety předpověděl sovětský jasnovidec německého původu Wolf Messing
- Největší krádež století za bílého dne!
- Drahý prezident
- Ivan Kratochvíl -Rada míru a perly z DAVOSU
- Komentář ruského prezidentského asistenta Jurije Ušakova po Putinově setkání s Witkoffem, Gruenbaumem a Kushnerem v Kremlu.
- Evropa našla svého "spasitele" od Trumpa a Putina.
Související články